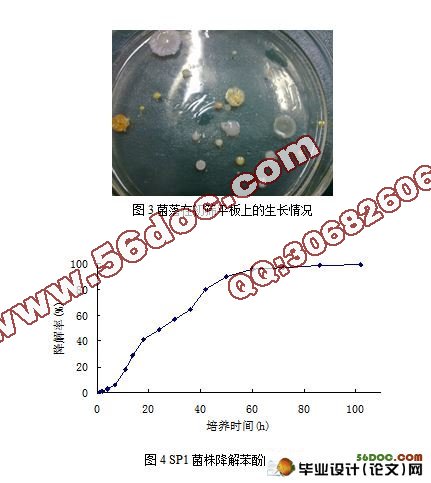

高浓度高效降酚菌的筛选及降解特性研究
来源:56doc.com 资料编号:5D10209 资料等级:★★★★★ %E8%B5%84%E6%96%99%E7%BC%96%E5%8F%B7%EF%BC%9A5D10209
资料以网页介绍的为准,下载后不会有水印.资料仅供学习参考之用. 密 保 惠 帮助
资料介绍
高浓度高效降酚菌的筛选及降解特性研究(8400字)
摘 要:本研究从湖南衡阳陶瓷厂的高浓度含酚工业废水中筛选出100多株苯酚降解微生物,有20多株能够在苯酚浓度高于1500mg/l的选择培养基中生长。其中10株对苯酚的耐受能力高于2000 mg/L,一株被命名为(SP1)的菌株最高耐受浓度可达3000 mg/L,实验结果表明:当苯酚浓度为2500 mg/L时,该菌株在60h降解率达95.9%。环境因素对SP1菌种降解苯酚试验结果表明,筛选获得的降酚微生物菌株的最适生长条件为25℃-40℃、pH5.0-9.0。外加氮源﹑碳源对该菌降解效率和生长状况都有不同程度的影响。外加氮源对其降解效率有促进作用,且有机氮源的作用强于无机氮源;而外加碳源则对其降解效率有抑制作用,加入葡萄糖﹑蔗糖和淀粉时,SP1的降解率分别下降了16%﹑21.5%和32%。
关键词:生物降解;苯酚;降酚菌;降解特性
Screening of Phenol-degrading Strains and
Study on Its Characterization
Abstract: In this study, More than one hundred of phenol-degrading microorganisms were isolated from industrial wastewater and soils containing high concentration phenols sampled from a Hengyang ceramic factory, Hunan province and more than twenty of isolated colonies could grow in the selective liquid medium with the initial phenol concentration higher than 1500 mg L-1. Among which ten of the isolated colonies could grow at the initial phenol concentration higher than 2000 mg L-1 and one of the isolated colonies named SP1 could grow at the initial phenol concentration higher than 3000 mg L-1. When the SP1 strain was cultivated at the initial phenol concentration of 2500 mg L-1, the phenol degradation rate at 60 h was 95.9%. The pH value, temperature, phenol concentration, nitrogen sources and carbon sources had significant effects on the phenol degradation rate and the cell growth of the SP1 strain. The optimal temperature of the SP1 strain was range from 25℃ to 40℃ and the optimal pH value was 5.0-9.0 . Additional nitrogen sources and carbon sources had significant effects on phenol degradation rate and cell growth of SP1 strain though to different direction and degree. The degrading rate of SP1 strain increased when additional nitrogen sources were added into the liquid medium containing phenol and the degraded rate of SP1 strain with organic nitrogen sources was higher than that with additional inorganic nitrogen sources. The additional carbon sources hinder phenol removal rate and cell growth of SP1 strain. The phenol degrading rate of the SP1 strain with glucose, sugar and starch decreased 16%, 21.5% and 32.0% respectively.
Key words: biodegradation, phenol,phenol-degradation strain,degrading characteristic


目 录
摘 要 1
关键词 1
1 前言 2
1.1 含酚工业废水概述 3
1.2 含酚废水的治理技术 3
1.3. 含酚废水脱酚处理技术的生物学研究趋势 3
2 材料与方法 3
2.1 实验所用培养基 3
2.2 样品的采集 3
2.3 高效酚降解菌种的筛选 4
2.3.1 菌种的富集 5
2.3.2 菌种的分离 5
2.3.3 菌种的纯化 5
2.3.4 高浓度高效降酚微生物菌株的筛选 5
2.4 高浓度降酚微生物耐受试验 5
2.5 SP1降酚微生物对苯酚的降解规律研究 5
2.6 SP1菌株降解特性研究 5
2.6.1 温度对降解率的影响 5
2.6.2 PH对降解率的影响 5
2.6.3 添加营养物质对降解率的影响 6
2.6.4 底物浓度对降解率的影响 7
3 结果与分析 7
3.1 高浓度降酚微生物的筛选及耐受性测定 7
3.2 SP1高浓度降酚菌的降解规律 7
3.3 SP1高浓度降酚菌的降解特性 8
3.3.1 底物浓度对SP1高浓度降酚菌降解苯酚的影响 8
3.3.2 温度对SP1高浓度降酚菌降解苯酚的影响 8
3.3.3 PH值对对SP1高浓度降酚菌降解苯酚的影响 9
3.3.4 营养物质对SP1高浓度降酚菌降解苯酚的影响 9
4 结论 11
参考文献 11
致谢 12
|